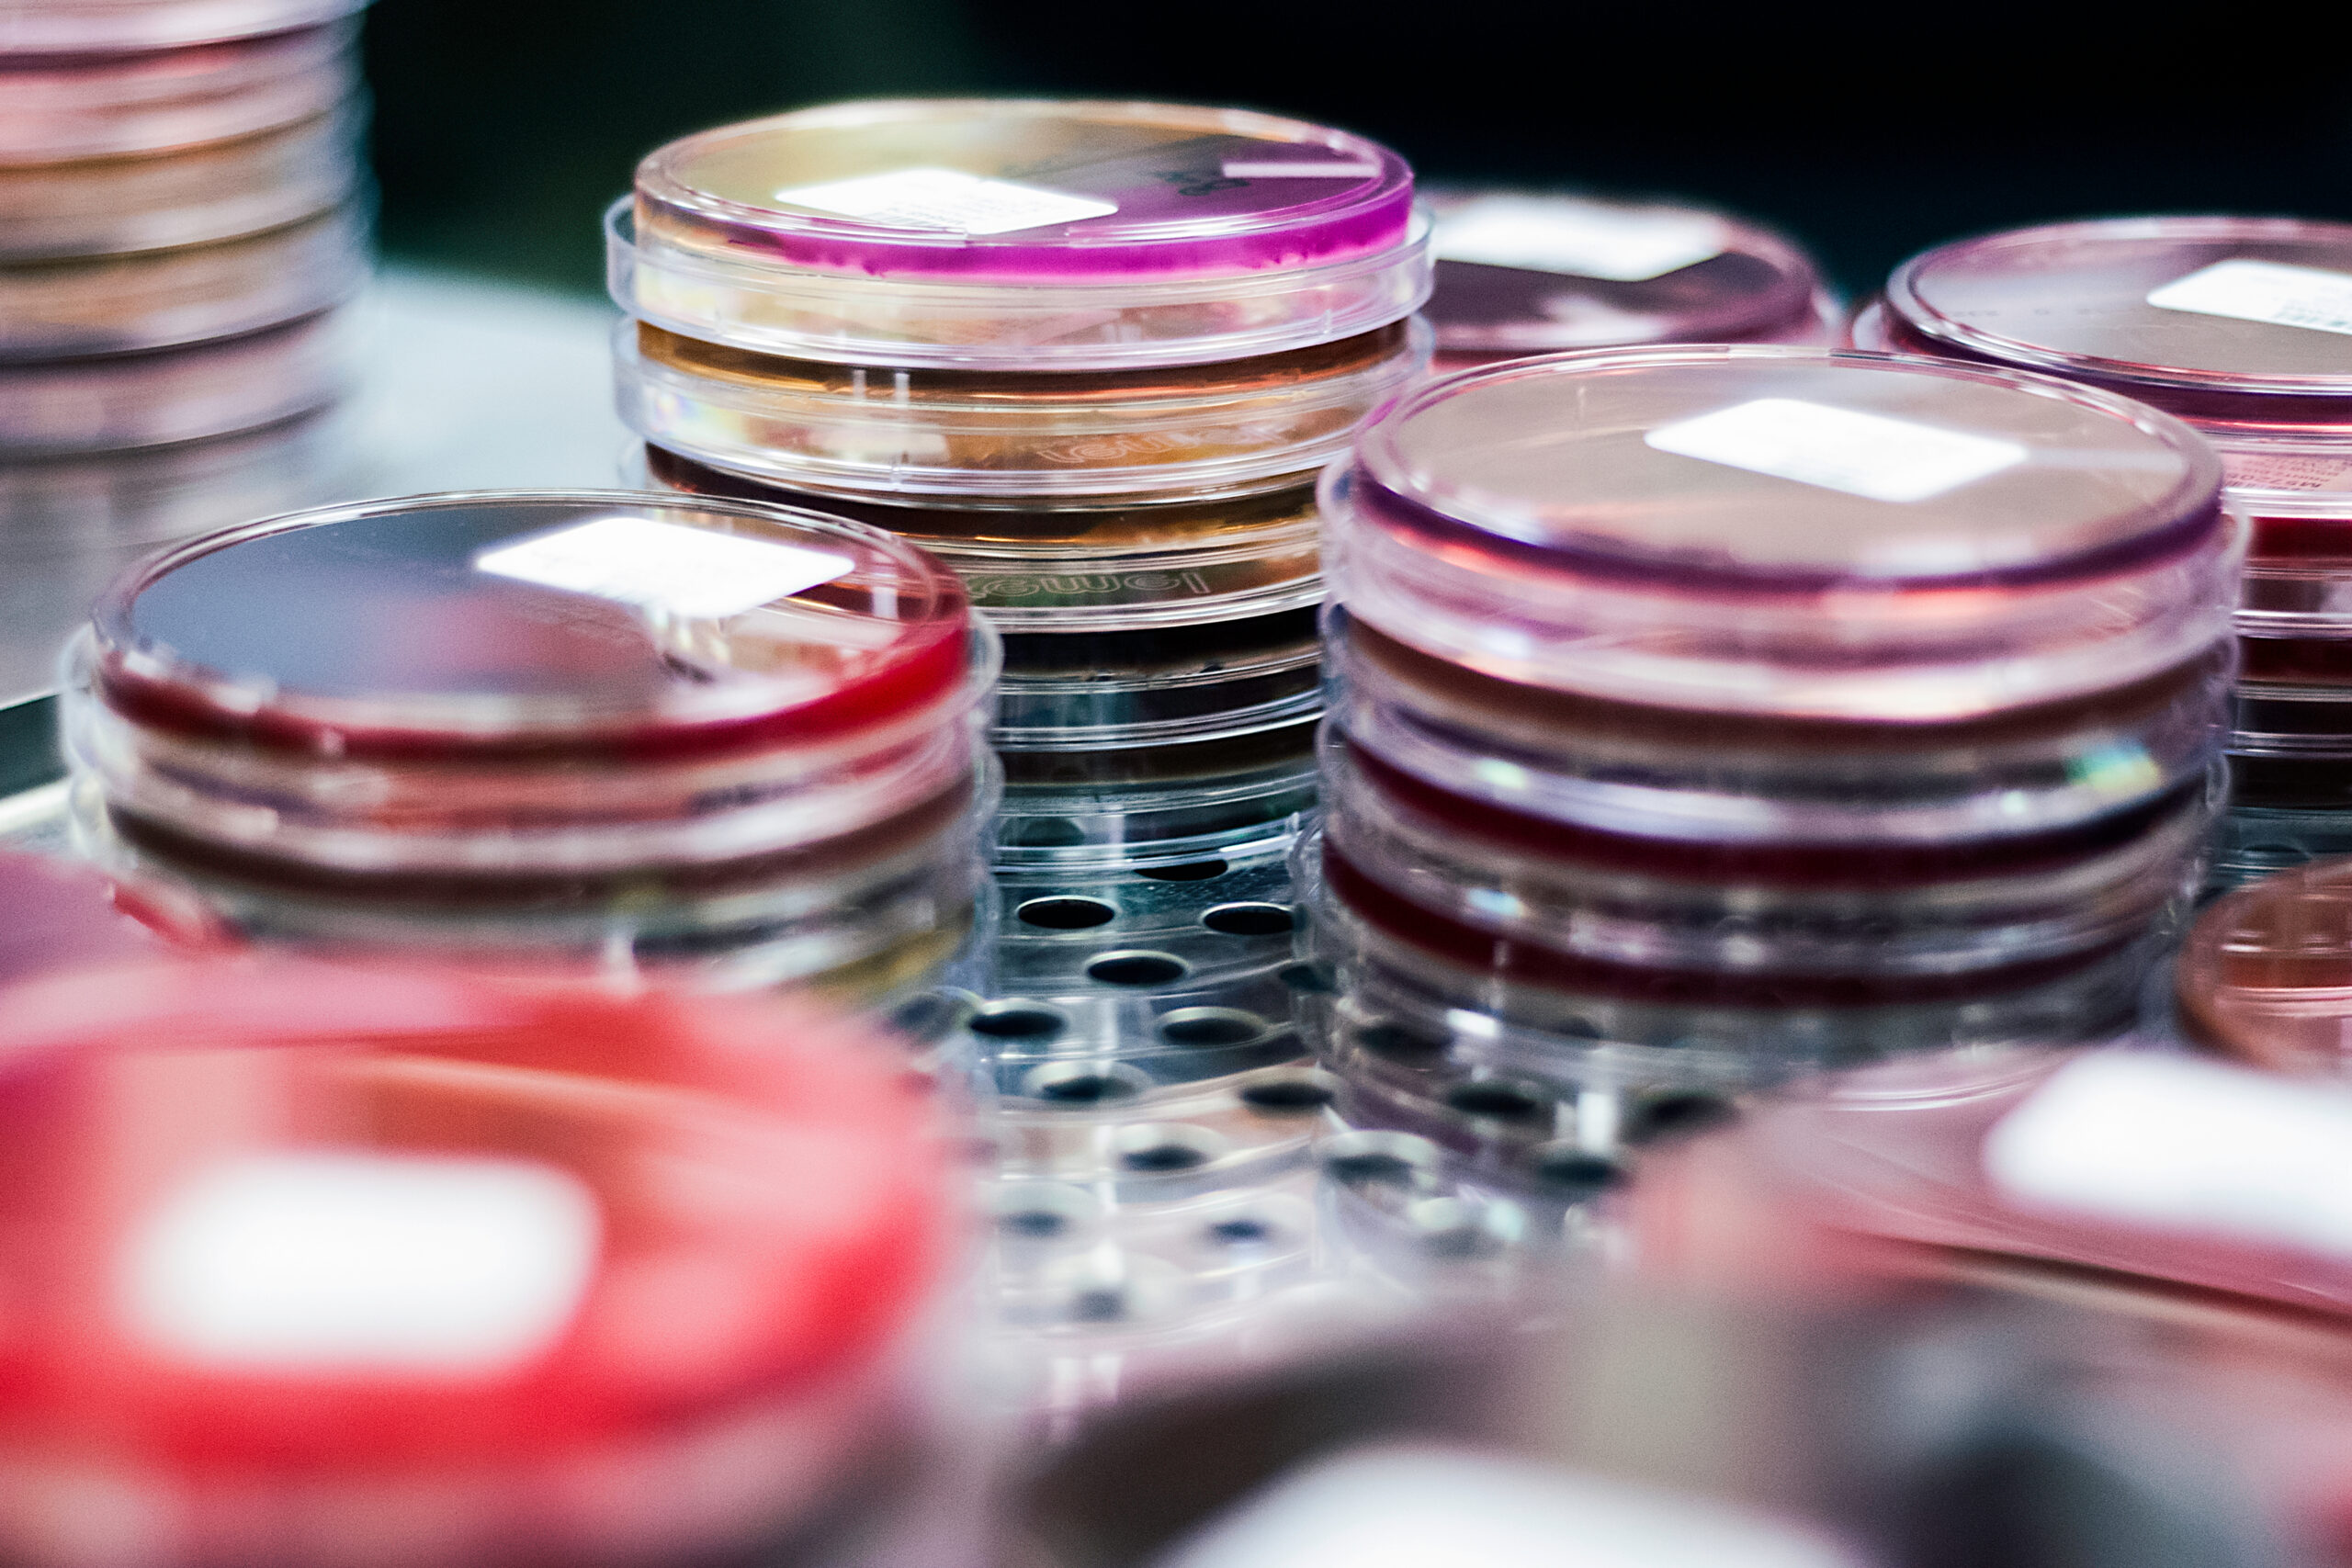

¿Qué es la infección por clostridium difficile (C. diff.)?
El clostridium difficile (C. diff.) es un tipo de bacteria que vive en el intestino de muchas personas. El C. diff. es parte del equilibrio normal de bacterias en su organismo. También vive en el medio ambiente, como en el suelo, el agua y las heces de los animales.
Read More
La mayoría de las personas nunca tienen problemas con el C. diff. Sin embargo, si hay un desequilibrio en sus intestinos, el C. diff. puede comenzar a crecer fuera de control. Las bacterias comienzan a liberar toxinas que irritan y atacan el revestimiento de los intestinos. Esto es lo que conduce a los síntomas de una infección por C. diff.
Síntomas de infección por clostridium difficile (C. diff.)
Las infecciones por C. diff. pueden variar de leves a graves.
Los síntomas leves pueden incluir:
- Diarrea acuosa (3 o más veces al día durante varios días).
- Dolor de estómago o sensibilidad.
Los síntomas graves pueden incluir:
- Diarrea frecuente y acuosa (hasta 15 veces al día).
- Dolor de estómago o sensibilidad intensos.
- Náuseas.
- Pérdida del apetito.
- Fiebre baja de hasta 101 °F en niños o de 100 °F a 102 °F en adultos
- Sangre o pus en las heces.
Llame a su médico si:
- Los síntomas comienzan después de tomar un antibiótico.
- Los síntomas duran más de 3 días o empeoran.
¿Qué causa una infección por Clostridium difficile (C. diff.)?
El factor de riesgo más común para C. diff. es el uso de antibióticos. Los antibióticos pueden alterar el equilibrio normal en sus intestinos. Su riesgo aumenta si ha tomado antibióticos durante un período prolongado o si el antibiótico es de amplio espectro (trata una gran variedad de bacterias).
Las personas de 65 años de edad o mayores tienen un mayor riesgo de contraer una infección por C. diff. Otros factores de riesgo incluyen:
- Cirugía del tracto gastrointestinal (GI).
- Cirugía de estómago que requiere mover los intestinos a un lado.
- Una estadía en el hospital.
- Vivir en un hogar de ancianos o en un centro de atención extendida.
- Problemas de colon, como el síndrome inflamatorio intestinal (SII) o el cáncer colorrectal.
- Tener un sistema inmunológico debilitado.
- Tener una infección previa por C. diff.
Si goza de buena salud, es probable que no tenga una infección por C. diff.
¿Cómo se diagnostica la infección por Clostridium difficile (C. diff.)?
Su médico necesitará analizar una muestra de heces para diagnosticar la C. diff. Es posible que se necesiten pruebas de seguimiento para confirmar. Su médico puede hacer una radiografía o una tomografía computarizada (TC) de su colon.
Puede dar positivo en una prueba de infección por C. diff. sin tener ningún síntoma. Esto se conoce como colonización C. diff. Algunas personas son portadoras de C. diff. pero no tienen C. diff. Un resultado positivo de la prueba más los síntomas indican que tiene una infección activa por C. diff.
¿Se puede prevenir o evitar la infección por clostridium difficile (C. diff.)?
Una infección por C. diff. es contagiosa. La bacteria puede propagarse de persona a persona. También viven mucho tiempo en superficies, como asientos de inodoros, teléfonos y picaportes. Una buena higiene puede ayudarlo a evitar la bacteria.
- Lávese bien las manos con agua y jabón.
- Use guantes desechables cuando cuide a alguien que pueda tener C. diff.
- Use productos a base de cloro para desinfectar superficies y artículos.
- Lave la ropa que pueda estar sucia con heces con jabón y lejía.
- Si visita a alguien en un centro de atención médica, lávese las manos antes, durante y después de su visita.
- No use antibióticos a menos que su médico los recomiende.
Si tiene una infección por C. diff., lávese las manos con agua y jabón antes de comer y después de usar el baño. Use un producto a base de lejía para limpiar las superficies que pueda haber tocado, para evitar transmitir la infección a otras personas. Aproximadamente 1 de cada 5 personas que tienen C. diff. la tendrán de nuevo.
Tratamiento de la infección por clostridium difficile (C. diff.)
Si estaba tomando un antibiótico cuando comenzaron los síntomas, su médico probablemente le pedirá que deje de tomarlo. Si tiene diarrea grave, lo vigilarán para que no se deshidrate. Alrededor del 25% de los pacientes comienzan a mejorar de 2 a 3 días después de suspender el antibiótico que causó la infección.
Para casos severos, su médico puede recetarle una dosis de 10 días de un antibiótico que haya demostrado su eficacia en el tratamiento de las infecciones por C. diff. Los ejemplos incluyen metronidazol y vancomicina. Debe mejorar después de 72 horas de comenzar el medicamento, aunque la diarrea puede continuar. En alrededor del 15% al 35% de los casos, se necesita una segunda ronda de antibióticos.
Mientras se recupera, tome muchos líquidos para reemplazar lo que su cuerpo perdió debido a la diarrea. Evite los productos lácteos y los alimentos que contienen harina de trigo o que son ricos en fibra. Su tracto digestivo puede ser sensible a ellos durante unos días.
Vivir con una infección por clostridium difficile (C. diff.)
Si su infección empeora, puede deshidratarse o no poder defecar. En casos raros, la C. diff. puede provocar sepsis (una infección sanguínea potencialmente mortal) o una punción en los intestinos.
Si tiene diarrea y cree que podría ser causada por C. diff., consulte con su médico antes de usar medicamentos antidiarreicos. Estos medicamentos pueden empeorar su infección.
Ciertos probióticos, o «bacterias buenas», pueden ayudar a prevenir la repetición de infecciones por C. diff. Hable con su médico antes de tomar cualquier suplemento. Puede indicarle qué tomar junto con los antibióticos.
Preguntas para hacerle a su médico
- ¿Debo dejar de tomar mi antibiótico? ¿En qué punto?
- Si tengo diarrea, ¿cuándo debo llamar a mi médico?
- ¿Cómo me contagié la infección por C. diff.?
- ¿Qué tratamiento es el mejor para mí?
- Si he tenido C. diff una vez, ¿cuál es mi riesgo de contraerla nuevamente?
- Mi madre está en un hogar de ancianos que tiene un brote de C. diff. ¿Debería hacerse la prueba?
- Me diagnosticaron como portador de C. diff. ¿Qué precauciones debo tomar con mis amigos y familiares?
- Tengo diverticulitis. ¿Estoy en riesgo de contraer una infección por C. diff.?
ADVERTISEMENT
ADVERTISEMENT